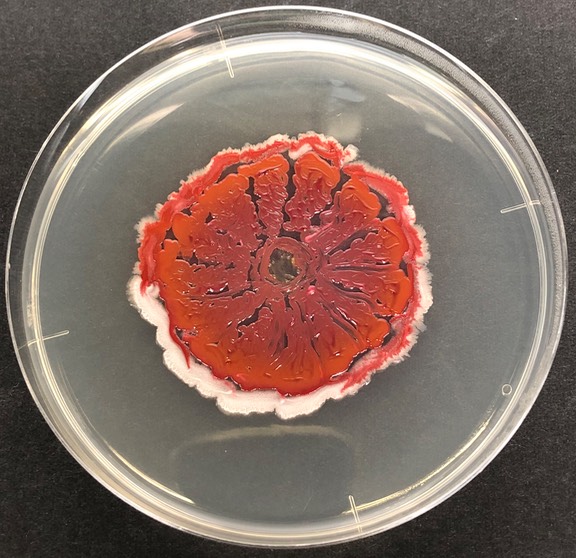

2023.3.30. 富士の国やまなしプロジェクトプレゼミ Joint-seminar of IFO project

発酵研究所の研究室助成で生命工学科・地域食物科学科・環境科学科の5研究室が参加する「富士の国やまなし微生物ライブラリーの構築と利用技術開発研究・教育の基盤形成」プロジェクトが採択され、環境科学科・田中研究室のM2の学生さんに研究内容を発表してもらいました。
振盪機 Repairing Shakers



振盪培養器の修理完了。上に載っているプレート台が回転もしくは往復振盪する機械で、微生物を培養する際に試験管やフラスコを振盪(して培地を攪拌)するのに使います。最近はできない方も増えているようですが大槻の世代はとりあえず自分で直す、が基本です。緑の粘着シートが載っているほうはモーター自体がお亡くなりになってしまったので稼働台はそのまま活用してモーターを交換したのですが30年前の低電流型モーターで現存品がなく現在入手可能なものに付け替えた関係でコントローラーが外付けに(笑)
でも、こんな機械でも1台20万円以上するのでウチのような貧乏研究室は苦労して使い続けます。
番外編 Athletic Meeting of Tyrannosaurus?



今期は修論・卒論発表の学生さんの勇姿を取り損ねました・・・ごめんなさいm(_ _)m
そのかわり、どころか全く関係ありませんが県内で行われたティラノサウルスレース山梨Vol.2「オトナとコドモの恐竜大運動会」に大槻が参戦しました。次はラボ全員で出たいですね。
基礎ゼミ学生の作品 Agar Art by Undergraduate Students

環境科学科・田中先生の取り組みに刺激されて、前期の学科1年生の生命環境基礎ゼミの一環で自分の手から分離した微生物を用いて微生物アートを描いてもらいました。皆さん植菌ループの扱いに慣れるのが早く、力作揃いとなりました!
2022.3.18. 卒業式 Graduation FY2021


今年度は3名が学士(生命工学)、1名が修士(農学)の学位を授与されました。おめでとうございます! 学士2名はさらに修士をめざします。社会人になる2名も、頑張れ!
卒業式 Graduation FY2020

2021年3月23日 新型コロナウイルスに翻弄された1年でしたが、頑張って研究を進め、博士課程1名、修士課程3名、学士課程3名(3名とも進学ですが)が巣立ちました。おめでとうございます!










